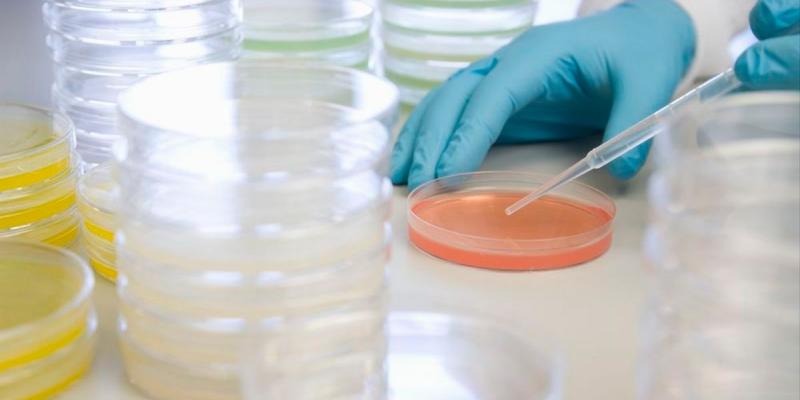
Sanidad descarta que sea cólera la infección detectada en Toledo

Lectura fácil
El Ministerio de Sanidad ha respondido ante los rumores sobre un posible caso de cólera después de que una niña consumiese agua no tratada en una finca de Toledo, algo que por el momento solo se debe a una infección gastrointestinal, aunque la bacteria causante es la misma.
El primer caso de origen autóctona detectado en España desde 1979
Este miércoles pudimos ver una noticia de última hora donde se afirmaba que en Toledo se había detectado un caso de cólera después de que una niña consumiese agua no tratada procedente de un sistema de canalización de una finca, la cual está ahora precintada. Sin embargo, el Instituto de Salud Carlos III, encargado de realizar las pruebas, determinó que este caso era Vibrio Cholerae 01 no toxigénico, por lo que “no se considera un caso de cólera”.
Aun así, las fuentes sanitarias señalaron que esta gastroenteritis por Vibrio procedía de la misma bacteria, pero no se trata de un caso específico.
A su vez, se han realizado todo tipo de acciones, tanto de salud publica como de coordinación entre las administraciones implicadas. Por ello, tuvo lugar un análisis y control de la zona y de las aguas del inmueble de la Comunidad de Castilla-La Mancha.
Esta noticia la adelantó El País y fuentes sanitarias de El Diario la confirmaron. Según pudieron conocer, la menor -residente en Madrid- consumió agua del grifo sin tratar y tuvo que ser hospitalizada al encontrarse mal. En el peor de los casos, se trataría del primer caso de origen autóctona en España desde 1979.
Todos los casos han sido importados
En los últimos años, todos los posibles casos de cólera han sido importados Según señalan desde el Instituto Carlos III, “en nuestro país el cólera no supone una amenaza importante esto se debe a la elevada cobertura de los sistemas de agua potable y saneamiento”.
En la zona de Navarra se declaró en 2017 un caso importado de la India; en 2018, Cantabria notificó otro caso procedente de la India; y La Rioja igual. Los seis casos que se notificaron fueron importados de inmediato.
Una infección benigna y con un riesgo “casi nulo”
Según recuerdan desde el Instituto Carlos III, el cólera es una enfermedad infecciosa intestinal aguda, diarreica, causada por la bacteria Vibrio cholerae. Esta infección es generalmente benigna o asintomática, aunque se calcula que el 5 % de las personas infectadas pueden llegar a sufrir una enfermedad grave.
Entre los síntomas destaca la diarrea acuosa profusa, vómitos y entumecimiento de las piernas. La pérdida rápida de líquidos corporales lleva a la deshidratación, colapso circulatorio y shock. Alrededor del 35-50 % de los casos de cólera son mortales si no se da un correcto tratamiento.
Su transmisión puede darse por la ingestión de agua o alimentos contaminados con la bacteria y puede afectar a niños y adultos, llegando a ser letal en apenas unas horas. Aun así, la mayoría de los casos, por no decir todos, pueden tratarse de forma satisfactorias a través de la administración de rehidratación oral.



Añadir nuevo comentario